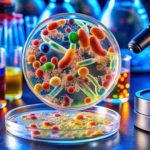

A palavra-chave “iogurte grego” voltou ao centro das atenções nos Estados Unidos após uma ação judicial contra a Chobani LLC, uma das maiores fabricantes do país. A marca, conhecida por sua imagem de produtos naturais e de origem simples, foi acusada de propaganda enganosa depois que testes laboratoriais identificaram compostos químicos associados a plásticos em seus iogurtes.
A denúncia, movida por Amy Wysocki, gerou intensa repercussão nacional e abriu um debate sobre transparência, segurança alimentar e ética publicitária na indústria de laticínios. Segundo o processo, os testes revelaram a presença de quatro tipos de ftalatos — DEHP, DEP, DBP e DEHT —, substâncias utilizadas para tornar plásticos mais flexíveis e resistentes.
De acordo com a Agência de Proteção Ambiental dos Estados Unidos (EPA), esses compostos são potencialmente cancerígenos e podem interferir no sistema endócrino. Os resultados foram confirmados por laboratórios independentes de Nova York, reforçando a credibilidade das alegações.
Tradição versus transparência
Fundada em 2005, a Chobani construiu sua reputação com base na história do imigrante turco Hamdi Ulukaya, que transformou uma pequena fábrica em Nova York em um império do iogurte grego avaliado em bilhões de dólares.
O sucesso da marca foi impulsionado pela promessa de “ingredientes simples e naturais”, slogan que agora se vê ameaçado.
A ação judicial acusa a empresa de violar leis federais e estaduais de proteção ao consumidor, por supostamente promover uma imagem enganosa de pureza e naturalidade. As acusações incluem propaganda falsa, violação de garantia e enriquecimento ilícito.
Associações como o Consumer Reports têm acompanhado o caso e apontam um aumento nas denúncias de alegações falsas de “naturalidade” em produtos industrializados — uma tendência que pressiona o setor a rever suas estratégias de marketing.
Os riscos invisíveis dos ftalatos
Especialistas da Universidade de Harvard alertam que os ftalatos podem migrar das embalagens para os alimentos, especialmente sob calor ou exposição prolongada, comprometendo a segurança do produto.
Estudos relacionam a exposição crônica a esses compostos a problemas hormonais e de desenvolvimento cognitivo em crianças, além de riscos reprodutivos.
O caso reacende uma questão central para o consumidor moderno: até que ponto é possível confiar em rótulos que se autodenominam “naturais”?
Autoridades sanitárias como a Food and Drug Administration (FDA) monitoram o desenrolar da ação e poderão, a partir desse processo, estabelecer novas diretrizes para rotulagem e controle de contaminantes.
Não é o primeiro escândalo
Em 2023, a Chobani já havia enfrentado outra ação judicial envolvendo seu “Iogurte Zero Açúcar”. O produto, que alegava não conter açúcares adicionados, incluía alulose, um adoçante natural que ainda é considerado açúcar pela legislação de alguns estados norte-americanos.
Na época, a empresa foi acusada de induzir consumidores ao erro, embora o caso tenha sido resolvido fora dos tribunais.
Até o momento, a Chobani não se pronunciou oficialmente sobre a nova denúncia. O silêncio da empresa tem sido interpretado como uma estratégia para avaliar o impacto da repercussão pública antes de adotar uma posição.
Entre confiança e desconfiança: o futuro do iogurte grego
A ação coletiva contra a Chobani não é apenas uma disputa judicial — é um reflexo das mudanças nas expectativas dos consumidores. Em um mercado em que transparência e autenticidade se tornaram diferenciais competitivos, a presença de compostos plásticos em produtos alimentícios desafia a confiança construída ao longo de décadas.
Especialistas do Congresso Nacional de Segurança Alimentar dos EUA defendem que rótulos claros e honestos são fundamentais para preservar a credibilidade do setor e garantir decisões de compra conscientes.
À medida que marcas tradicionais enfrentam escrutínio, a indústria de alimentos vive um dilema entre manter a tradição e adotar práticas modernas de transparência.
O caso Chobani pode marcar um ponto de virada para o mercado global de iogurtes gregos, forçando uma revisão profunda nos processos de produção, rotulagem e controle de qualidade.
*Escrito para o eDairyNews, com informações de Em foco